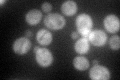
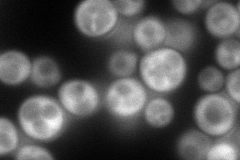
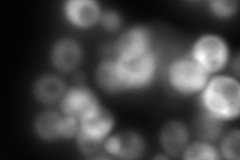
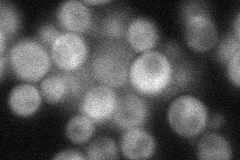
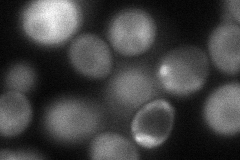

View description
Cytoplasmic ankyrin-repeat containing protein of unknown function, proposed to link the processes of 40S ribosomal subunit biogenesis and adaptation to osmotic and oxidative stress; expression repressed by heat shock
Localization:
Intensity:
Fold change:
Significance:
-
C’ GFP library in SD
cytosol80.94 -
N' NOP1pr-GFP in SD
cytosol145.636 -
N' TEF2pr-mCherry in SD
cytosol0 -
N' NATIVEpr-GFP in SD
cytosol38.9481 -
N' TEF2pr-VC and Cyto-VN in SD
cytosol72.5379 -
C’ GFP library in SD+DTT

cytosol57.830.71No -
C’ GFP library in SD+H2O2

cytosol59.240.73No -
C’ GFP library in Starvation Media

cytosol54.350.67No -
C’ GFP library on the background of Pup2-DaMP

cytosol -
C’ GFP library on the background of CCT mutant

cytosol70.20790.867334No
